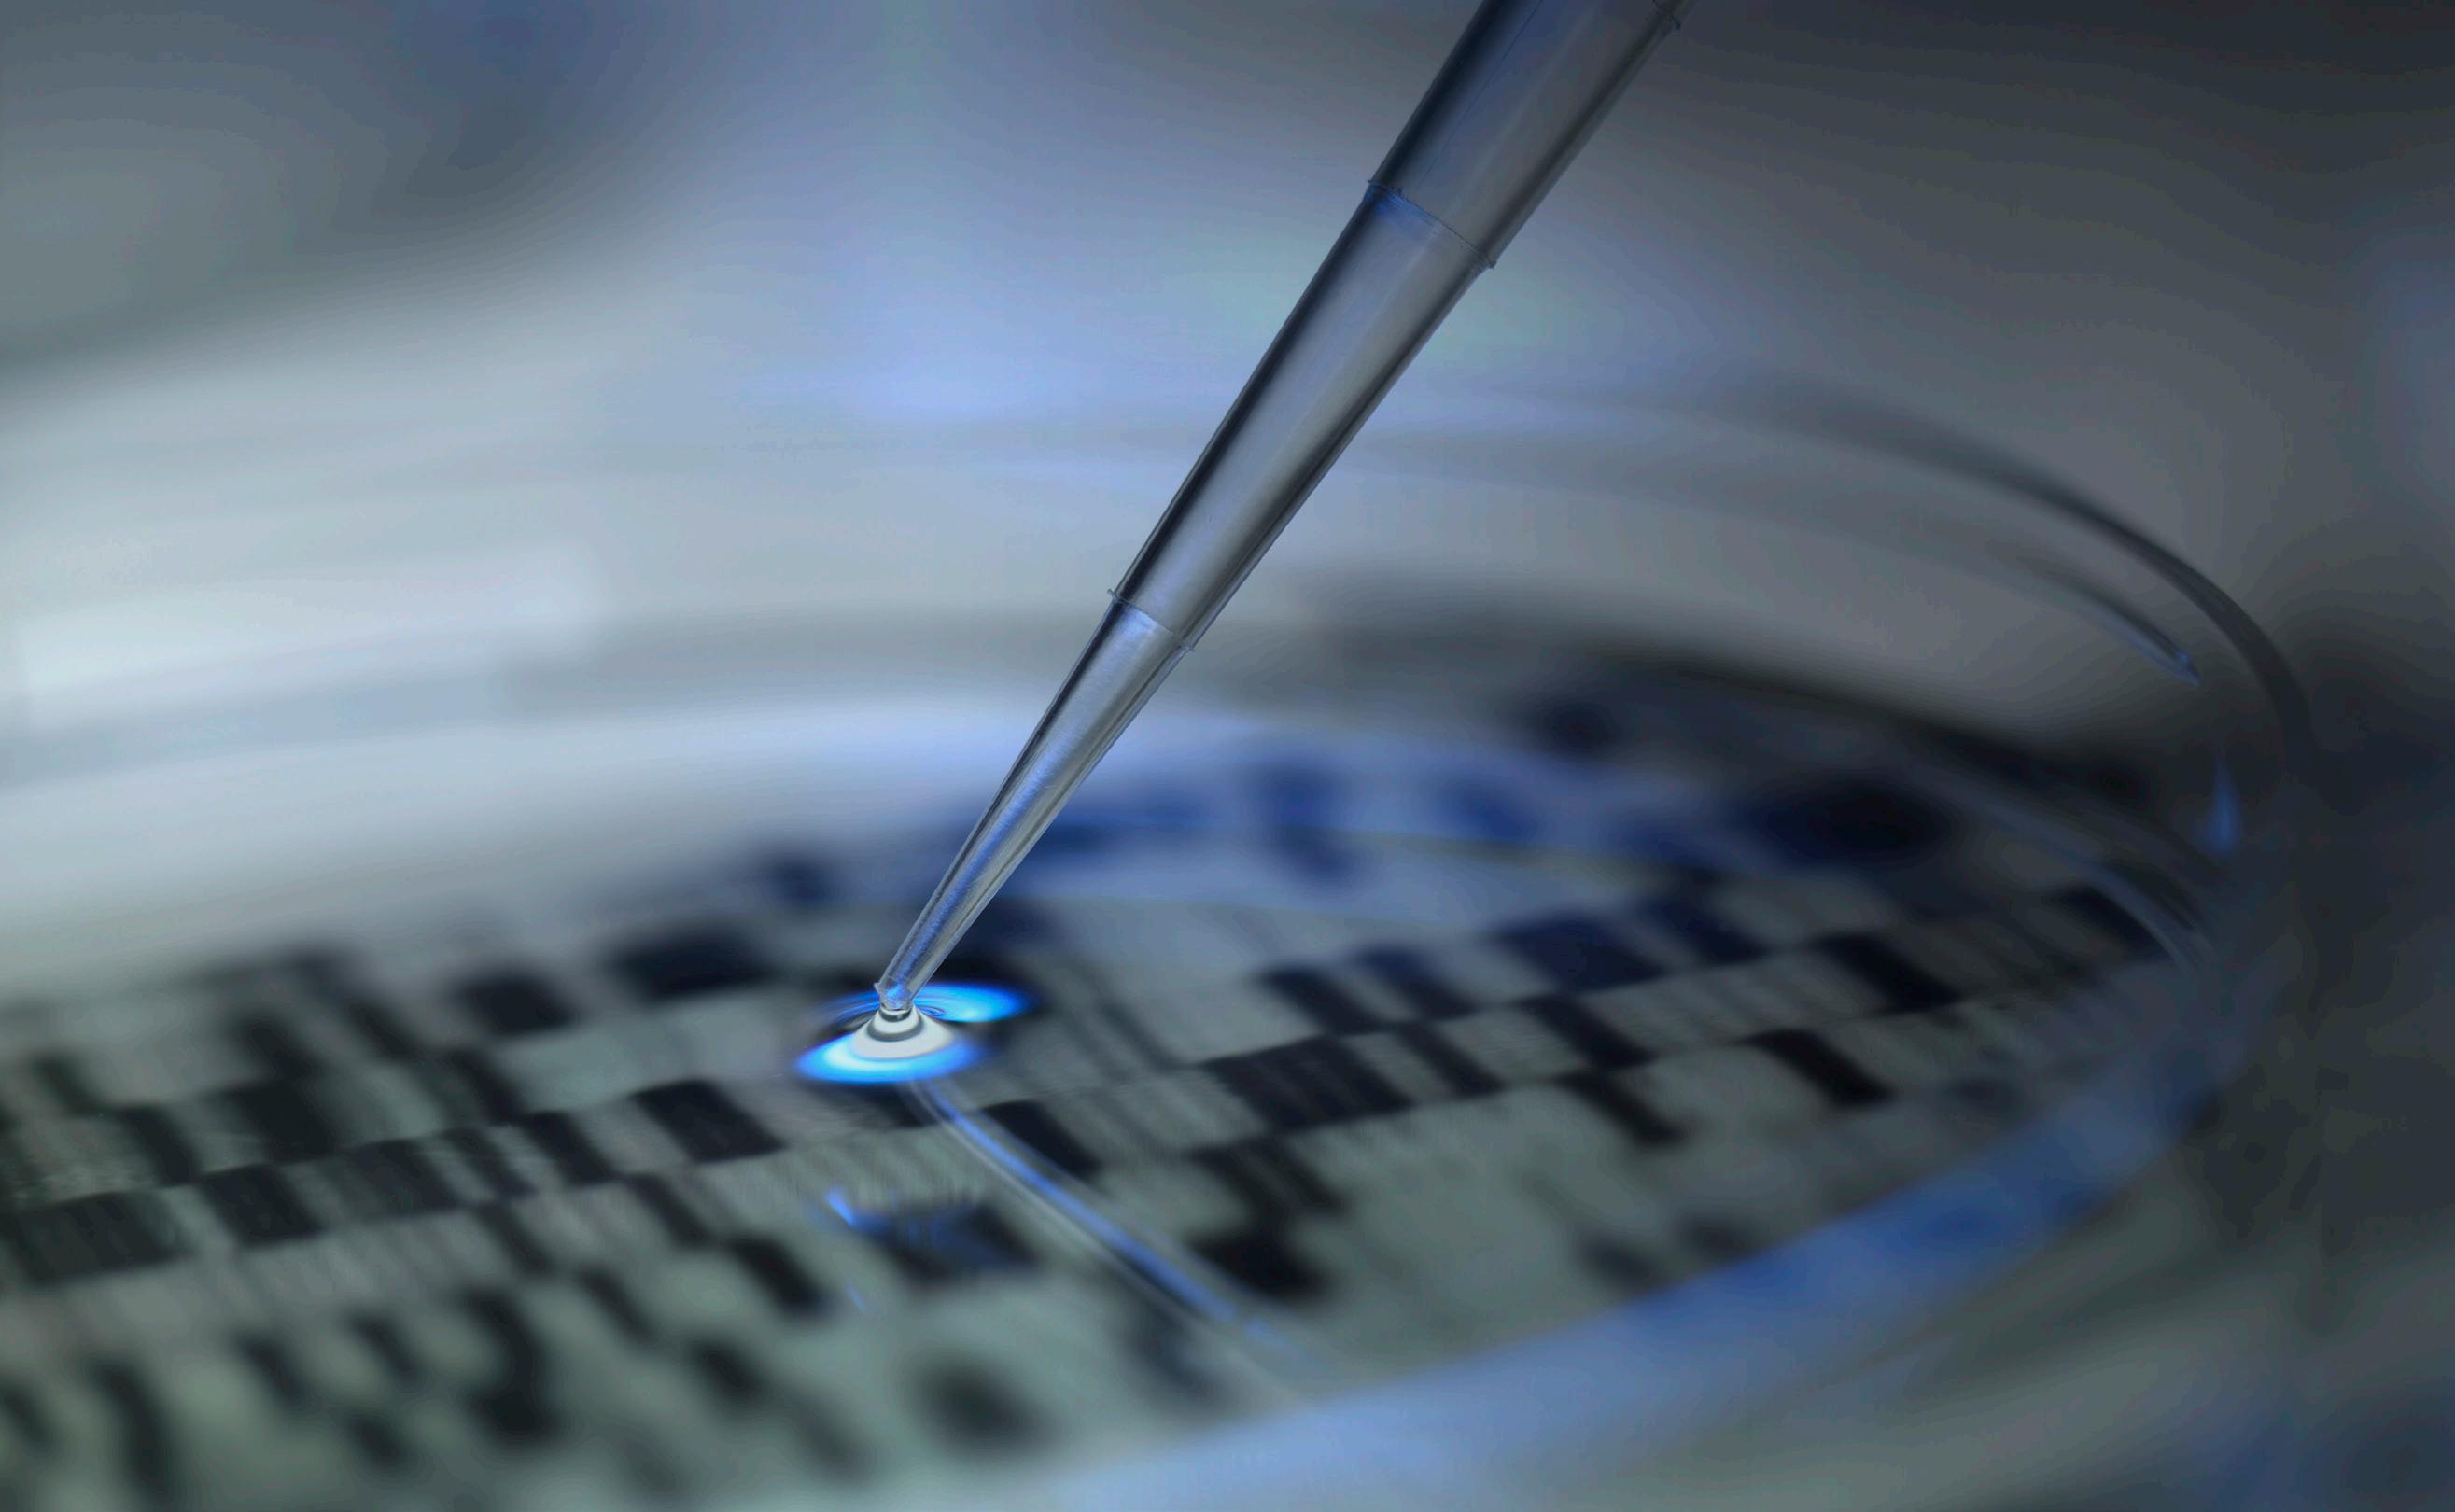

AN INITIATIVE
sparking collaboration and innovation
Nearly five years ago, we formally announced the launch of an initiative. Our goal was to support collaboration and mentorship that would lead to groundbreaking, transdisciplinary research for the improved health of Kentuckians and beyond.
We called this the “Alliance Research Initiative.” In 2018, we launched three pilot alliances, and due to their success, we launched another round in 2020 – this time, with 18 teams. I am incredibly excited about what we have witnessed so far.
We have had tremendous success in bridging cross-college and cross-University partnerships to create space for translational science. With combined expertise, our teams are addressing the state’s most urgent health needs such as cancer, cardiovascular disease, diabetes and obesity, neuroscience, and substance use disorder.
Not only are we bringing physicians and scientists together but also faculty and trainees in other specialties such as agriculture, education, engineering, nursing, pharmacy, public health, and many more. In total, there are 24 College of Medicine departments and nine UK colleges represented in our Alliance teams. Some teams actually have up to four colleges represented.
Additionally, the Alliance Research Initiative is connecting trainees and early-career faculty with experts who can assist in grant writing, data analysis, clinical trials, and more. Utilizing the power of mentorship, we are shaping future generations of innovators. These are connections that may not have been forged had there not been a formal structure in place to make them happen.
And the work continues. This January, we welcomed four more teams to the initiative through Alliance 2.0. They are hitting the ground running: obtaining grants, providing mentorship, and facilitating important research just six months in. These teams will work toward advancements in biomedical education, maternal and pediatric health care, mobile health, and stroke research.
During our Alliance event, we will hear directly from mentees regarding their Alliance teams and how they are contributing.
These successes surely reflect the benefit of our Alliance Research Initiative. But success is truly made possible by the amazing faculty, staff, and learners at the UK College of Medicine and beyond who are helping the initiative reach its full potential and improve health care for patients.
Rebecca Dutch, PhD Vice Dean for Research
The following groups will be on site to provide resources and information:
Proposal Development Office (PDO)
Center for Clinical and Translational Science (CCTS) College of Medicine medical illustrators
UK Innovate
Undergraduate Research
Philanthropy

Alliance Research Initiative Event: October 4, 2023
Opening Remarks | Becky Dutch, PhD
FINDERS | Jihye Bae, PhD
BRAIN | Gabriela Aparicio, PhD
CATSS | Jordan Harp, PhD
ADAM | Saurav Das, MD, Nirmal Verma, PhD
MAMMA | Mikhail Koffarnus, PhD, Carolyn Lauckner, PhD
KRALD | Alex Flannery, PharmD, PhD
Break
CURE | Kirby Mayer, DPT, PhD
VITAL | Jeremy Wood, PhD
Poster Presentations
Lunch Break
MYRA | Andrew Kolodziej, MD
SPORE | Ashfaqul Alam, PhD
ADORE | Samir Softic, MD
AIM | Yuan Wen, MD, PhD
TRIPPPLe | Elizabeth Rhodus, PhD
Break
LIFT | Seth Himelhoch, MD, MPH
MaPRA | Robin Shoemaker, PhD
PERFORM | Xiaoqi Liu, PhD
UK-AARC | Hisashi Sawada, MD, PhD
ABE | Beth Garvy, PhD
OAK | David Landy, MD
TILT | Roberto Gedaly, MD, Francesc Marti, PhD
Closing Remarks | Becky Dutch, PhD
ABE
Alliance of Biomedical Educators

An important goal of the College of Medicine Map to Impact through a Transdisciplinary Strategy (COMMITS) is to “strengthen the quality and distinction of our educational programs.” ABE is designed to provide an organized effort to systematically target grant funding opportunities across multiple funding agencies, provide shared resources to optimize budgets, coordinate professional development activities, share knowledge to minimize barriers, and provide training to faculty who are interested in writing educational grants. Our biomedical education programming has benefitted from individual faculty members committed to training the next generation of scientists and physicians developing externally funded programs designed to give underrepresented high school, undergraduate, and graduate students opportunities to be immersed in biomedical research. They have taken advantage of granting programs through NIH, NSF, and other organizations.
Many of these funded projects are targeted to underrepresented populations in the sciences. ABE is designed to provide an organized effort to systematically target grant funding opportunities across multiple funding agencies, provide shared resources to optimize budges, coordinate professional development activities and provide training to faculty who are interested in writing educational grants.
Principal Investigators
2 1
Publications
Grant Submitted
$2,429,695
TOTAL FUNDING
Beth Garvy, PhD Luke Bradley, PhDAlliance for Reduction of Diabetes Associated Microvascular Dysfunction
If left untreated, diabetes can lead to cardiovascular disease, renal disease, stroke, and cognitive decline. All are serious problems related to microvascular dysfunction, a condition that causes the small blood vessels to work poorly, reducing blood flow to the heart, brain, and other parts of the body.
With the support of the UK College of Medicine’s Alliance Research Initiative and Neuroscience Research Priority Area, the ADAM will work to integrate research efforts to uncover how microvascular dysfunction develops. The team’s goal is to advance the discovery of new treatments of disorders –including type-2 diabetes, cardiovascular disease, and cognitive decline – involving this condition.

ADAM’s team is already at work on a critical clinical study. One of the effects of microvascular dysfunction in type 2 diabetes is a painful condition called peripheral neuropathy, damage to the nerves outside the brain and spinal cord. Patients can experience pain, a pins-and-needles sensation, numbness, and weakness, usually in the hands and feet. ADAM members are conducting research on patients to determine if the level of amylin, a hormone that aids in digestion, is related to the severity of this condition.
Study participants have a small amount of skin scraped from their forearm and a blood sample collected before undergoing a series of sensation tests in the arms and hands. The results may identify a correlation between the amount of amylin present in the blood and skin of the forearm and the extent of the peripheral neuropathy. If so, researchers will have gained an important insight into possible treatments for the condition.
Principal Investigators
10
4
Publications
Grants Submitted
$5,525,818 TOTAL FUNDING
Alliance for Diabetes and Obesity Research
Kentucky’s adult obesity rate has climbed dramatically over the last two decades. The state now has the fifth highest adult obesity rate in the nation – 36.6 percent, up from 21.7 percent in 2000 – and the third highest obesity rate for youth ages 10 to 17. Obesity is far more complicated than a simple accumulation of fat. The metabolic changes that occur with obesity result in an increase in cardiovascular risk factors, poor bone quality, and insulin resistance. This last complication is directly related to 13.8 percent of Kentucky’s adult population having diabetes.
With the support of the UK College of Medicine’s Alliance Research Initiative and the Diabetes and Obesity Research Priority Area, ADORE will bring together a transdisciplinary team of investigators at the University of Kentucky to focus on obesity and diabetes, conditions that contribute substantially to the chronic disease burden of our state’s citizens.
Obesity is far more complicated than a simple accumulation of adipose tissue. The metabolic changes that occur with obesity result in insulin resistance, an increase in cardiovascular risk factors, inflammation in many tissues, poor bone quality, and lipotoxicity of muscle and the liver. Hepatic lipid accumulation leads to steatohepatitis, a type of fatty liver disease which is a leading cause of cirrhosis. Abnormalities in muscle lead to insulin resistance and poor physical function. Inflammatory changes in adipose, muscle, liver, and blood may be an important cause of many obesity-related conditions, including type 2 diabetes, cancer, and cardiovascular disease.
Future research directions will include surgical interventions for weight reduction coupled with new findings that will lead to personalized and targeted therapies for the treatment of obesityrelated comorbidities. ADORE is a response to recognized research gaps in knowledge and the need for more research in this focus area as it relates to health care disparities in Kentucky. The alliance will bring together a transdisciplinary team of senior and junior investigators at the University of Kentucky to leverage a broad spectrum of metabolic research talent to focus on obesity and diabetes as they contribute to the chronic disease burden of our citizens.
Principal Investigators
Simon Fisher, MD, PhD
Phil Kern, MD
Barbara Nikolajczyk, PhD William Inabnet, MD251 77
Publications
Grants Submitted
$18,880,704 TOTAL FUNDING
PIs Simon Fisher and Barbara Nikolajczyk were selected internally at UK to submit an application for a proposed Phase I Center in Biomedical Research Excellence (COBRE) grant with an overarching theme of “Diabetes Prevention” (CDP)
Creation and establishment of the Bariatric Tissue Bank – Drs. Barbara Nikolajczyk and Phil Kern (ADORE), Drs. Barry Inabnet and Josh Steiner (UK College of Medicine Department of Surgery), and the Center for Clinical and Translational Science (CCTS), set up a bariatric tissue bank to allow investigators interested in the effect of diabetes and obesity on the function of human adipose tissue, liver, and immune cells, amongst others. Tissue collection is in process and ongoing.

Artificial Intelligence in Medicine
Artificial intelligence (AI) and machine learning (ML) are transforming biomedical research and health care delivery, enhancing clinical care, and speeding scientific discovery. The recent coalescence of big data, accelerated computing, and deep learning has yielded remarkable results across research discovery and translational medicine. AI has emerged as a promising tool to improve patient outcomes and reduce cost by providing insights from clinical data across medical domains, including cancer, neuroscience, aging, substance use disorder, etc..
To develop AI methods for transdisciplinary research in medicine, investigators need programmatic access to data, methods to correlate records, and expert knowledge to curate the data across domain-specific repositories. AIM will advance data-driven science across health-centered research priority areas (RPAs) and potentially open new areas of transdisciplinary research inquiry on AI application in medicine. Our initial work will focus on radiology, pathology, and laboratory data to support UK’s strategic RPAs. We also have formal collaborations with the Markey Cancer Center, the Sanders-Brown Center on Aging, and the Institute for Biomedical Informatics.
Principal Investigators

25
5
Publications
Grants Submitted
$11,478,991 TOTAL FUNDING
BRAIN
Brain Restoration Alliance in Neurodegeneration
The human body has enormous healing powers, yet damage to nerve cells caused by accident or neurodegenerative disorders such as Parkinson’s disease might lead to irreversible scarring and even death of the cells, resulting in permanent weakness and difficulty in moving limbs.
With the support of the UK College of Medicine’s Alliance Research Initiative and Neuroscience Research Priority Area, BRAIN has been investigating a process to heal damaged nerve cells. The team’s research will focus on the Schwann cells that surround all nerve fibers in the peripheral nervous system (outside the brain and the spinal cord) and form myelin sheaths around the nerve fibers to protect them. Schwann cells support the repair and growth of damaged axons. There is a possibility that Schwann cell activity could be used to repair damaged nerve cells in the brain and spinal cord.
As part of forming an alliance among the labs of Drs. van Horne, Gerhardt, and Voss, BRAIN explored the transcriptomics, proteomics, and cellular changes of human peripheral nerve regeneration. The results obtained from these investigations paved the way for the initiation of the most recent stage of clinical trials, known as the GUIDE trial, which employs peripheral nerve tissue to potentially intervene in the progression of cellular degeneration in Parkinson’s disease.
Principal Investigators

27 14
Publications

Grants Submitted
$17,728,128 TOTAL FUNDING
Center of Advanced Translational Stroke Science
CATSS was launched in 2014 and now has a refocused scientific goal to study acute and long-term biomarkers for stroke-induced cognitive decline in our patient population. The CATSS is a scientific working space that pulls together clinicians and basic scientists to collaborate and advance the field of stroke research in translational and innovative ways. As a team, we have published 15 peer-reviewed publications, and presented over 50 abstracts at national and international meetings. This includes publishing with over 16 trainees (residents; graduate, medical, and undergraduate students), with all publications including junior faculty authors.
The goal for CATSS over the last three years has been to provide an externally funded, multidisciplinary, translational, and interactive environment for the exploration of mechanisms, diagnostics and therapeutics for hemorrhagic and ischemic stroke. To accomplish this, we extensively use our prospectively enrolling tissue bank, the Blood and Clot Thrombectomy Registry and Collaboration (BACTRAC; NCT03153683). With this procedure, we collect the thrombi during mechanical thrombectomy (MT), clinical and radiographic data and long-term cognitive assessments. Our ultimate goal is to create a database that incorporates both clinical patient data with biological biomarker data as a recruitment tool for rehabilitative studies, as stroke is a global leading cause of long-term adult disability.
This Clinical Stroke Consortium is designed to support the scientific and professional development of junior faculty. Dr. Glueck will focus on virtual reality (VR) as a rehabilitation paradigm for BACTRAC stroke patients at 1 year or longer following thrombectomy, with 149 patients currently available to contact for recruitment. This team approach will include long-term cognitive assessments (Harp), and biomarker analyses in blood draws (Trout), with final critical statistical analyses to identify biomarkers of injury, or potentially positive responses to rehabilitation (McLouth) in these patients. These data will also be foundational as preliminary data for several external grant applications outlined below. With the successful Alliance support, we have also recruited other junior faculty to collaborate and promote networking within the UK research community, as well as individual professional development.
Principal Investigators
8
2
Publications
Grants Submitted
$908,000 TOTAL FUNDING
COVID-19 Unified Research Experts
COVID-19, an infectious disease caused by the virus now known as the severe acute respiratory syndrome coronavirus 2 (SARSCoV-2), was first detected in Wuhan, China, in December 2019. The virus spread globally at a rapid rate and was declared a global health emergency by the World Health Organization (WHO) in January 2020, and a pandemic in March.
In response, the University of Kentucky has gathered leading researchers from the colleges of medicine, pharmacy, public health, health sciences, engineering, and nursing to coordinate campus-wide efforts to research the virus and find the most effective treatments and, ultimately, a cure.
With support from the UK College of Medicine’s Alliance Research Initiative, CURE is focusing on SARS-CoV-2 and COVID-19 to enhance research, clinical trials, and clinical care at UK.
Several clinical trials sponsored by CURE are already underway. These include a phase 2 trial of new methods for treatment of high-risk COVID-19 positive patients and preventive measures for front-line physicians and hospital patients during the pandemic. CURE will also design potential studies of repurposed drugs that may be of benefit to patients testing positive for COVID-19 and advise on important medical policies, including consideration for compassionate use of these repurposed drugs in particular treatments.
Principal Investigators
Ilhem Messaoudi, PhD Vincent Venditto, PhD155
11
Publications
Grants Submitted
$12,700,000 TOTAL FUNDING
Clinical Trials
1. The adaptive, multi-arm phase 2 trial of novel agents for the treatment of high-risk COVID-19-positive patients
2. The Povidone-Iodine Intranasal for Prophylaxis in frontline physicians and inpatients during the SARS-CoV-2 pandemic (PIPPI) trial
FINDERS
Functional Imaging for NeuroDiagnostics for Epilepsy and Resective Surgery
Determining seizure type and locating where a seizure occurs in the brain makes it possible for physicians specializing in epilepsy to decide on the most appropriate treatment, including surgery. When the site of the seizure can be found rapidly and accurately by EEG, MRI, and other means of neuroimaging, physicians can diagnose and treat patients quickly and effectively. But in many cases traditional EEG and MRI techniques are unable to accurately locate where a seizure arises in the brain, limiting surgical treatment options.
Funded by the UK College of Medicine’s Alliance Research Initiative and support from Neuroscience Research Priority Area, FINDERS works to improve the treatment of epilepsy by bringing advanced neuroimaging techniques into use in the clinic. The goal of the FINDERS alliance is to improve localization of seizures, diagnosis, and treatment options through the development of new brain imaging methods. An important part of meeting that goal is the gathering of a transdisciplinary team of researchers and clinicians. Accordingly, FINDERS will pull together clinical collaborators including radiologists, neurologists, neurosurgeons, neuropsychologists, as well as neuroscientists, neuroimagers, physicists, biostatisticians, and other researchers from the colleges of medicine, engineering, and public health.
One remarkable and advanced form of neuroimaging to be used by the FINDERS alliance combines two familiar methods: EEG and MRI. EEG alone can identify epilepsy but has poor spatial resolution that limits identifying the focus of the seizure, which often lies deep in the brain. MRI has good spatial resolution throughout the brain, including deep regions, but it is not specific to epilepsy. When combined, however, the strengths of the two methods produce a neuroimaging technique that works better than either one alone in the identification of seizures, ultimately providing a better guide for surgical treatment options.
FINDERS will also support clinicians to compete successfully for grants. Mentorship by established scientists will provide these clinicians the training and resources to become clinical investigators, advancing their skills and improving the treatment of epilepsy patients in Kentucky.
Principal Investigators
Brian Gold, PhD Meriem Bensalem Owen, MD14 7
Publications
Grants Submitted
$7,533,377 TOTAL FUNDING
Kentucky Research Alliance for Lung Disease
Lung disease is the third leading cause of death in the U.S. and a significant health problem in Kentucky. The incidence of asthma in the state is among the highest in the nation, and chronic obstructive pulmonary disease (COPD) is a major cause of death for Kentuckians. In addition, acute respiratory distress syndrome (ARDS), a severe form of acute lung injury (ALI), is one of the most frequent causes of admission into the intensive care unit. While there are many outstanding scientists and clinicians at the University of Kentucky College of Medicine who address specific aspects of lung disease, there has not been a unified program to bring lung disease researchers together.
With support from the UK College of Medicine’s Alliance Research Initiative and the Vice President for Research Emerging Research Themes program, K-RALD draws together basic scientists, clinician scientists, and public health researchers from a wide range of specialties to promote translational lung research from the bench to the bedside and into the community.
The members of K-RALD have created a lung biobank for use in research, led by Jamie Sturgill, PhD, assistant professor in the Department of Microbiology, Immunology, and Molecular Genetics. Until now, there was no biobank on campus that collected lung tissue, blood, and/or alveolar fluid in the context of any lung diseases other than lung cancer. The newly formed Lung Biobank includes biosamples from a wide range of lung diseases, supporting research on additional forms of pulmonary dysfunction. Basic and clinical scientists are able to collaborate with the Lung Biobank in small pilot studies made possible by K-RALD funds, leading to new research, the development of more effective treatments, and improved care of all lung patients in Kentucky and beyond.
Principal Investigators
519 100+ $43,000,000+ TOTAL FUNDING
Grants Submitted
Executive Committee:
Christopher Waters, PhD, Director
Lu-Yuan Lee, PhD, Basic Science Director
Mehdi Khosravi, MD, Clinical Director
Joseph Zwischenberger, MD, Translational Science Director
Jamie Sturgill, PhD, Biobank Director
Christine Trinkle, PhD
Robust biobank and registry of specimens linked to de-identified patient clinical data, enrolling over 130 patients with over 100 samples in storage, that have provided key preliminary data for R01 and R21 applications
Clinical trial involvement - PETAL Network, NEXIS Trial, STRIVE Network, DRIVE Trial
Monthly Seminars and Research-inProgress Series
Leveraging Clinical and Behavioral, Biomedical and Policy Innovations to Facilitate Tobacco Treatment in Kentucky Principal
Smoking is the leading preventable cause of death in Kentucky. Kentuckians smoke at nearly 1.5 times the rate of the general adult population, with the highest prevalence in the rural east. These alarming smoking rates are associated with a higher incidence of cancer, cardiovascular disease, diabetes, and stroke.
The single greatest health behavior change that would improve health and decrease mortality in tobacco users is to quit smoking and using other tobacco products. But the usual methods for smoking cessation – pharmacological, clinical, and bio-behavioral interventions – are less successful in rural areas, in part because of a shortage of health care providers, the pressing needs of the opiate crisis, and the rise in use among young people of non-combusted forms of nicotine (i.e., e-smoking, vaping). To begin to reduce tobacco use and promote health equity requires a multi-pronged, multidisciplinary approach aligning the skills and interests of policy researchers, researcher scientists, community leaders, and the public.
With support from the University of Kentucky College of Medicine’s Alliance Research Initiative and Cancer/SUPRA Research Priority Area, LIFT KY will create innovative, multidisciplinary clinical, behavioral, biomedical, and policyrelated research with the aim of reducing tobacco use in rural Kentucky and beyond.
UK receives prestigious Tobacco Centers of Regulatory Science (TCORS) grant
UK’s Appalachian Tobacco Regulatory Research Team (AppalTRuST) has a goal to investigate the impact of Federal Drug Administration Center for Tobacco Products (FDA CTP) regulatory policies in rural communities through collaboration, education and pioneering regulatory scientific research.
AppalTRuST is comprised of a highly collaborative group of investigators representing five colleges at the University of Kentucky (medicine, nursing, public health, education and arts and sciences), two University centers (Markey Cancer Center and BREATHE), and the Pacific Institute of Research and Evaluation (PIRE) Louisville Kentucky Center. AppalTRuST will provide scientific resources to evaluate the effects of the introduction of novel products and potential restrictions on flavored and high-nicotine products in rural communities so that regulatory decisions are made using a health equity lens.
Investigators
71 10
Publications
Grants Submitted
$24,450,000 TOTAL FUNDING
Clinical Trials
1. Optimizing smoking cessation treatments in smokers living with HIV/ AIDS in Nairobi, Kenya.
This RCT will enable us to evaluate the most promising behavioral and pharmacologic treatments aimed at achieving maximal efficacy for smoking cessation among people living with HIV/AIDS who are in methadone maintenance and smoke in Nairobi, Kenya.
2. Optimizing smoking cessation treatments in smokers living with HIV/ AIDS.
This RCT will enable us to evaluate the most promising behavioral and pharmacologic treatments aimed at achieving maximal efficacy for smoking cessation among people living with HIV/AIDS who smoke.
mHealth Application Modernization and Mobilization Alliance

Smartphone applications to promote healthy behaviors (mHealth apps) are exploding in popularity with the increasing ownership rates of smartphones. mHealth apps excel at realtime data collection and interventions that can be delivered in the user’s natural environment. mHealth apps of this type have been used by members of this alliance to measure health behaviors in natural environments to greater understand the causes of disease, as well as to deliver efficacious behavioral interventions to improve unhealthy behavior.
Despite the dramatic potential impact of mHealth apps designed to assess specific theories and deliver custom interventions, there are substantial and often overwhelming barriers to entry for junior investigators interested in using mHealth apps in their research. The development of a successful mHealth app requires expertise in treatment delivery, behavioral science, assessment methods, user interface design, programming, database management, and data privacy. Furthermore, while the intended use of each app varies, many of the technical implementation challenges are common and do not necessarily need to be reinvented. These multifaceted skillsets require a team science approach, and often a large expenditure of resources that is unobtainable for a junior faculty member who is just beginning to seek extramural funding to support their work.
The overall goal of this alliance is to leverage the knowledge, experience, and skillset of the transdisciplinary alliance members to create resources that can be used by junior faculty and others new to mHealth research. Through mentorship, linkage to existing resources, and assistance with customized protocols for our existing mHealth platform, we will facilitate the development of research programs in faculty new to mHealth research. We expect that these efforts will also lead to new grant funding among these new faculty, as well as among teams of senior and junior faculty who can leverage a robust smartphone app platform to propose large-scale, collaborative grants.
Principal Investigators
Mikhail Koffarnus, PhD Carolyn Lauckner, PhDGrants Submitted 4
• 37 members across 9 colleges
• 46% of members are junior faculty or trainees
• 73% of members have no to little mHealth experience
MaPRA
Maternal and Pediatric Research Alliance
The medical care for pregnant women and children comprise a significant portion of UKHealthCare and UK College of Medicine and includes the UK College of Medicine departments of obstetrics and gynecology (division of maternal fetal medicine) and pediatrics, along with Kentucky Children’s Hospital. These clinical services are in many cases regionally vital to residents of the state of Kentucky. Most of these clinical settings have been strengthened and expanded in recent years.
Kentucky’s Children’s Hospital has experienced unprecedented growth and it has taken a leadership role in Kentucky for most pediatric services, and especially high-risk pregnancy and level 4 NICU care. There is at this time an outstanding opportunity to leverage signature clinical programs by adding and aligning research activities to address healthcare needs in these special populations.
There is already strength and momentum in the settings of perinatal and pediatric research, much of it has been developed and supported by individual investigator teams. Expanding the investigator pool, and developing research theme and interest groups will catalyze new research growth and improve collaborative ties.

The goal of MaPRA will be to serve as a beacon across the UK campus for the development and support of research studies that address pregnancy, infancy, and childhood. This effort will provide value with respect to faculty retention and recruitment, training opportunities, external reputation, and additional funding support specifically dedicated to pregnancy and childhood. The long-term goal of this alliance will be to form a lasting unit that is self-sustainable, with ties to other already established entities.
Principal Investigators
Ilhem Messaoudi, PhD John O’Brien, MD Tom Curry, PhD Peter Giannone, MD25
Publications
$3,000,000
TOTAL FUNDING
John Bauer, PhDMyocardial Recovery Alliance
A critical part of advanced cardiac care, ventricular assist devices (VADs) are mechanical pumps that can maintain blood circulation in patients who have serious heart failure. VADs are often used to support patients who are awaiting a cardiac transplant. However, they can sometimes be used to rescue a patient’s failing heart. The VAD can then be removed, allowing the patient to return to their prior life. Rescuing the heart is known as myocardial recovery.
The UK College of Medicine and UK HealthCare are leaders in treating advanced heart failure, performing about one percent of heart transplants worldwide – more than 40 procedures each year – and deploying VADs at a similar rate.
With funding from the UK College of Medicine’s Alliance Research Initiative and support from the Cardiovascular Research Priority Area, MYRA will leverage existing clinical and scientific strengths at the institution to improve understanding of myocardial recovery. With support from bioengineers and geneticists, the translational research team will forge new collaborations to improve therapies for patients with heart failure. In the process, the team will create a transdisciplinary program in which clinicians and scientists interact daily and, importantly, influence each other’s work.
MYRA is already developing remarkable computer models of hearts that grow and evolve in response to pharmaceutical and genetic manipulation on the molecular level. The MYRA structure will build on Alliance Research Initiative support to use detailed knowledge of these molecular mechanisms to work towards improved patient care.
Principal Investigators
4 15
Publications
Grants Submitted
$2,500,000 TOTAL FUNDING
Dr. Vaidya: 10 papers since 2021, CARP, BUFFET, and AIM-HIGHER trials, Receipient of CCTS Career grant, 7 grant submissions
Dr. Kolodziej: 11 papers since 2021, REVERSE-HF trial, taking over CARP and AIM-HIGHER, starting Ventripoint trial and 1 grant submission
Osteoarthritis Alliance of Kentucky
Osteoarthritis is a deterioration of protective cartilage that cushions the ends of bones and affects more than 30 million Americans. Knee osteoarthritis is the most common joint disorder in the U.S. and a leading cause of disability and chronic pain. A related condition, post-traumatic osteoarthritis (PTOA), occurring after a traumatic joint injury, has increased over the last 10 years and represents the most common cause of military disability.
With funding from the UK College of Medicine’s Alliance Research Initiative and the department of orthopaedic surgery and sports medicine, college faculty and clinicians have joined to form the OAK. This transdisciplinary team will provide a structure combining skills and expertise to deliver a comprehensive treatment strategy.

As investigators who approach PTOA from diverse perspectives, OAK’s clinical scientist members will study the disease from molecular, joint, and whole-person perspectives to improve health-related quality of life within the Commonwealth and beyond. The collective expertise of the OAK clinician scientists and researchers uniquely positions the group to make significant advances in PTOA care.
Principal Investigator
David Landy, MD, PhD123
42
Publications
Grants Submitted
$14,684,129
TOTAL FUNDING
PERFORM
Prostate Expertise in Research For Overcoming Resistance and Mentoring
Prostate cancer is the second leading cause of cancer-related deaths in men in the U.S. Although the five-year survival for prostate cancer is high, about one-third of all patients experience relapse of the disease within three years, developing metastatic tumors in the bone, lung, and other tissues. Because there are currently no treatments to overcome the metastatic spread of prostate cancer disease, there is a critical need to discover new drugs or repurpose FDA-approved drugs to prevent or treat prostate cancer at all stages of development.
Funded by the UK College of Medicine’s Alliance Research Initiative and supported by the Cancer Research Priority Area, PERFORM has gathered an interdisciplinary team of investigators to better understand prostate cancer progression and to develop bench-to-bedside strategies to target metastatic disease. While researching the genomic alterations associated with the disease, and conducting bench-to-bedside translation of promising compounds, PERFORM’s senior faculty will mentor their fellow team members to support them in research and funding strategies.
PERFORM involves a partnership of multiple basic science departments (toxicology and cancer biology, molecular and cellular biochemistry, biostatistics, bioinformatics) and clinical departments (radiation medicine, urology, internal medicine, pathology) in the College of Medicine; chemistry in the College of Arts and Sciences; pharmaceutical sciences in the College of Pharmacy; various interdisciplinary centers; and the Kentucky Cancer Registry. All of PERFORM’s members are focused on prostate cancer research and/or treatment and bring unique backgrounds and experience to their shared work.
With the cooperation of the Markey Cancer Center and the Precision Medicine Clinic, PERFORM will secure research-grade testing of prostate tumors. The results will be used to develop methods to predict treatment resistance and identify the best matching treatments for prostate cancer patients. PERFORM also plans to offer a yearly workshop on enhancing the success of basic scientists and physician/surgeon-scientists, with the goal of increasing collaboration as well as the number of grants for prostate cancer research and treatment.
Principal Investigators
17 5 $11,547,233 TOTAL FUNDING
Grants Submitted
Vivek Rangnekar, PhD PublicationsRPTA
Radiopharmaceutical Therapy Alliance
With support from the Cancer Research Priority Area, RPTA completely aligns with the key strategic priorities of the University of Kentucky Markey Cancer Center (MCC) for increasing transdisciplinary collaborations related to radiation medicine science and clinical investigations. Charles Kunos, MD, PhD, leader of RPTA, directs the clinical radiopharmaceutical program in the department of radiation medicine and the MCC Clinical Research Office. He is in a strong position to support all endeavors of RPTA. All the proposed members of RPTA are either full or associate members of the MCC.
Cancer represents a significant health burden in the Appalachian Kentucky population, which is the defined “catchment population” for the MCC. RPTA will address specific topics related to genitourinary, gynecological, and gastrointestinal cancers. Therefore, the RPTA further aligns with the strategic objective of focusing on the most prevalent cancers in Kentucky and also a priority to increase the number of multidisciplinary grants in the MCC. Other goals of this alliance align entirely with the mission of providing mentorship to early-career investigators and to increase the number of clinical trials managed by MCC. As a result of the close alignment of RPTA and the MCC, the $100,000 provided by the Alliance Research Initiative will be matched by $100,000 in MCC funds.
Principal Investigator
Charles Kunos, MD, PhD Lowell Anthony, MD Zin Myint, MD10 5
Publications
Grants Submitted
2 National Cancer Institute Cancer Therapy Evaluation Program trials
SPORE
Specialized Program of Research Excellence in GI Cancers Alliance

Gastrointestinal (GI) cancers represent a significant problem in Kentucky, especially in the eastern rural part of the state. In fact, Kentucky has the highest incidence of colorectal cancer in the nation.
With the support of the UK College of Medicine’s Alliance Research Initiative and the Cancer Research Priority Area, SPORE is working to improve the prevention, diagnosis, and treatment of GI cancers. The SPORE alliance will introduce new risk prediction strategies for colorectal cancers based on epidemiology and genetics, increase earlier detection and diagnosis of pancreatic cancer, and develop new therapeutics in colorectal and liver cancers and GI neuroendocrine tumors.
The “team science” approach of SPORE extends beyond the boundaries of GI cancer research program to include critical collaborations with multiple UK colleges, affiliate hospitals, community providers, other institutions, networks, and industry.
Principal Investigators
72
22
Publications
Grants Submitted
$28,062,088 TOTAL FUNDING
Mark Evers, MD Tianyan Gao, PhDT Cells to Induce Liver Tolerance

TILT was recently created to support translational and clinical research in transplant/immunology related to the use of cell immunotherapy to induce tolerance in solid organ transplantation. The co-leaders of this alliance, Roberto Gedaly, MD, chief of the transplant center, and Francesc Marti, PhD, chief of the transplant cell immunotherapy program in the division of transplantation at the University of Kentucky, have been working together for more than six years. Their clinical and translational research program has established fruitful collaborations with other departments and divisions in our institution, including biochemistry; microbiology, immunology, and molecular genetics; radiology; biomedical engineering, internal medicine, hepatology, nephrology, and pathology. They are currently running a novel, FDA-approved, pilot study of adoptive transfer of ex vivo expanded regulatory T cells (Tregs) in kidney transplant recipients (ClinicalTrials.gov ID: NCT03284242). This is the only active clinical pilot study using Treg cells in solid-organ transplantation in the state of Kentucky and the Appalachian region and one of the only six active protocols using this technology in the U.S.
The ultimate goal is to eventually reduce or completely stop drug-induced immunosuppression, which has significant toxicity in patients. They are currently generating data addressing the implementation of a first-in-class clinical trial in liver transplant patients to induce hepatic tolerance. As part of this project, they are mentoring junior faculty from the departments of radiology (Aman Khurana, MD) and biomedical engineering (Fanny Chapelin, PhD). Currently, this collaboration focuses on the optimization and validation of a novel non-invasive cell tracking system for T cellbased immunotherapy using MR imaging. They are also working together with the biospecimen bank and tissue procurement shared resource facility of the Markey Cancer Center using the GEOMx digital spatial profiler platform to study the phenotypic and mRNA abundance of liver resident Treg cells in the normal and transplanted liver allograft.
Principal Investigator
34 10
Publications
Grants Submitted
$1,295,000 TOTAL FUNDING
Translations of Research Interventions in Practice, Populations, and Policy Leadership
Kentucky has one of the highest premature death rates in the nation, ranking in the top 10 for the leading causes of mortality including cancer, substance use, diabetes and obesity, and cardiovascular disease. Kentuckians from rural, largely underserved areas suffer disproportionately from these serious medical conditions and are among those most likely to die prematurely. Developing and delivering innovative and effective treatments is essential, particularly for those with the greatest needs. The challenge is to speed up the process of bringing important research discoveries made within a laboratory or other controlled settings into clinics and communities.
Funded by the University of Kentucky College of Medicine’s Alliance Research Initiative and support from multiple Research Priority Areas, TRIPPPLe will answer this challenge by applying the methods of dissemination and implementation to speed up the delivery of new and effective research interventions to a larger and more diverse population. TRIPPPLe will concentrate on promoting evidence-based research into the broader community through the practice of medicine, population health, and health policy. To meet these goals, the TRIPPPLe team is comprised of three cores, each with its own leader: administrative, methodology research, and training.
Principal Investigator
Matthew Bush, MD, PhD Hannah Knudsen, PhD Nancy Schoenberg, PhD112
36
Publications
Grants Submitted
$9,875,822 TOTAL FUNDING
UK-AARC
Aortopathy Alliance Research Center
Aortopathies, diseases of the aorta, cause specific regions of the aorta to pathologically dilate, dissect, or rupture, with high risk for death. There is no cure at present. Although there are advances in surgical treatment, mortality rate remains high because of the nature of the diseases and a lack of strong guidelines about the best time for the surgery.
With funding from the UK College of Medicine’s Research Alliance Initiative and support from the Cardiovascular Research Priority Area, UK-AARC will work to use the existing strengths of basic science researchers to enhance the translation of their research to the clinical and population arena, speeding the bench-to-bedside process. UK-AARC is especially focusing on research that will aid in the goal of developing effective pharmacological treatments as alternatives to surgery.
The translation of research into clinical practice depends on close interaction between basic science researchers and physician-scientists. The group has plans to work together on projects and to share data, benefiting both researchers and physicians. UK-AARC members will focus their first collaboration on a major goal, the development of an aortopathy-focused photoplethysmography, a device measuring blood flow, for use in clinical practice.

Principal Investigator
56
7
Publications
Grants Submitted
$8,926,520
TOTAL FUNDING
VITAL
Virus Induced Thrombosis Alliance
Thrombosis, the formation of clots in blood vessels, lies at the root of the causes of many cardiovascular disease deaths such as strokes, heart attacks, and deep vein thrombosis (DVT). Infectious disease can increase the chance of this coagulation dysfunction, and some viral infections, including HIV1+/AIDS, double the risk of occlusive cardiovascular disease.
With funding from the UK College of Medicine’s Alliance Research Initiative and support from the Cardiovascular Research Priority Area, VITAL is investigating why infections cause an increased risk of cardiovascular disease. The combination of cardiology and virology is critical, especially now, as the effect of COVID-19 on clotting becomes clear. VITAL’s initial focus on the thrombotic risks associated with HIV1+/AIDS has grown into a collaboration with the Bluegrass Care Clinic to examine coagulation dysfunction in COVID-19 patients.
VITAL has already launched clinical studies of monocytes, platelets, and coagulation factors in HIV1+/AIDS patients and SARS-CoV-2/COVID-19 patients with varying severity of disease. The researchers are beginning a longitudinal study on changes in hemostasis occurring during SARS-CoV-2/COVID-19 disease and recovery from it. While conducting these studies, VITAL is also reaching out internationally to establish a collaboration with the African Health Research Institute to expand analysis of patients with HIV1+/AIDS.

Principal Investigators
8
12
Publications
Grants Submitted
$2,689,876 TOTAL FUNDING
Beth Garvy, PhD Sidney Whiteheart, PhD